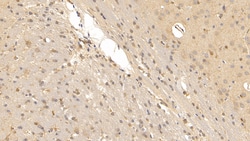
Invitrogen Relaxin 3 Monoclonal Antibody (D10) 200 &mu;L; Unconjugated:Antibodies,

missing translation for 'onlineSavingsMsg'
Learn More
Learn More
Invitrogen™ Relaxin 3 Monoclonal Antibody (D10)


Description
Relaxin 3 Monoclonal Antibody for Western Blot, ICC/IF, IHC (P)
Relaxin 3 is part of the Relaxin-like peptide family that plays an important neuropeptide signaling role. Relaxin 3 is a ligand for two structurally related G protein-coupled receptors, human Relaxin receptor 3 and Relaxin receptor 4. The greatest levels of Relaxin 3 expression occur in the brain, specifically in the pons/medulla, with highest levels in the pars ventromedialis of the dorsal tegmental nucleus and with lower levels in the hippocampus and olfactory regions. Significant expression is also observed in the spleen, thymus, lung and ovary. Relaxin 3 inhibits Forskolin-stimulated cAMP accumulation in a dose-dependent manner in cells that express Relaxin receptor 3. Acute and repeated administration of Relaxin 3 causes a decrease in levels of the plasma thyroid stimulating hormone, suggesting that Relaxin 3 may play a role in long-term control of food intake.

Specifications
Specifications
| Antigen | Relaxin 3 |
| Applications | Immunohistochemistry (Paraffin), Western Blot, Immunocytochemistry |
| Classification | Monoclonal |
| Clone | D10 |
| Concentration | 1 mg/mL |
| Conjugate | Unconjugated |
| Formulation | PBS with 50% glycerol and 0.05% ProClin 300; pH 7.4 |
| Gene | RLN3 |
| Gene Accession No. | Q8BFS3, Q8WXF3 |
| Gene Alias | H3; insl7; insulin-like 7; insulin-like peptide 7; Insulin-like peptide INSL7; M3; PRO20213; Prorelaxin H3; prorelaxin M3; relaxin 3; relaxin-3; Relaxin-3 A chain; Relaxin-3 B chain; RLN3; RXN3; UNQ6188; UNQ6188/PRO20213; ZINS4 |
| Show More |
Product Title
By clicking Submit, you acknowledge that you may be contacted by Fisher Scientific in regards to the feedback you have provided in this form. We will not share your information for any other purposes. All contact information provided shall also be maintained in accordance with our Privacy Policy.
Spot an opportunity for improvement?